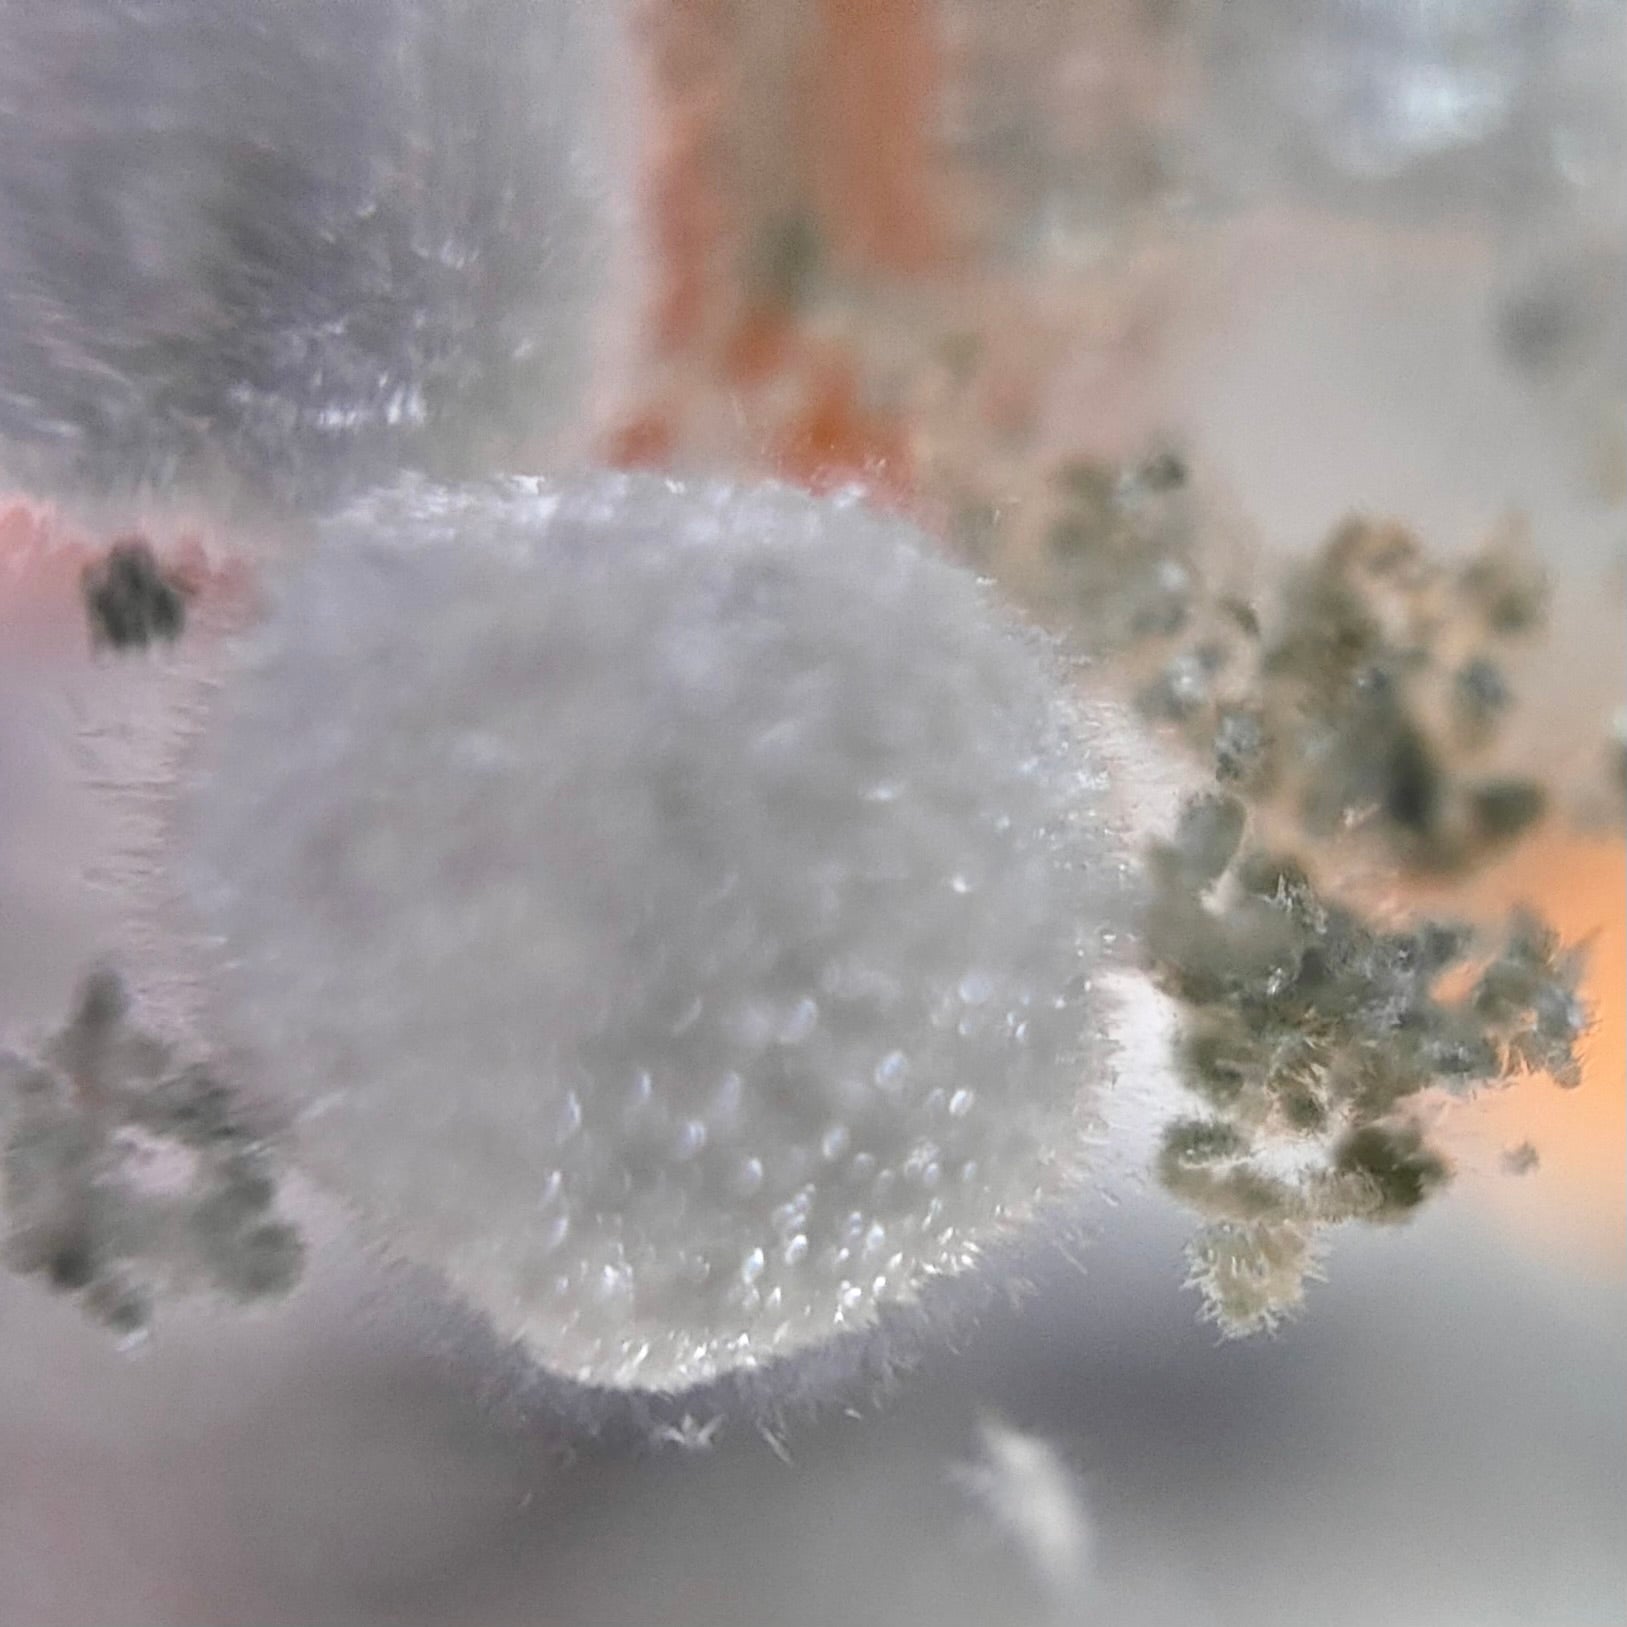

maggy holy gems
Bague Cristobalite blanche
Bague Cristobalite blanche
Rangée réductible
Rangée réductible
Les stocks pouvant fluctuer en raison des ventes en boutique, il est possible qu’un article commandé ne soit plus disponible. Dans ce cas, un remboursement sera effectué sans délai.
Impossible de charger la disponibilité du service de retrait
Bague Maggy Holy Gems
Cette magnifique bague est montée avec un quartz Cristobalite provenant du Brésil, avec des inclusions en forme de boules de neige blanche
Le cabochon de 12 carats de 2.2cm sur 1.2cm, est enchâssé dans de l'argent massif.
Chaque pierre est unique et a été soigneusement sélectionnée par Magali lors de ses voyages à l'étranger.
Les photos que vous voyez ont été prise sur cette pierre dont une avec microscope.
Plongez dans l'éclat mystique de notre bague avec quartz avec inclusions de Cristobalite,
une gemme rare associée à l'harmonie et à la clarté spirituelle.
Pierre dynamisante à l'énergie concentrée, elle équilibre les émotions.
Alliant élégance et lithothérapie, ce bijou unique stimule la méditation et l'alignement énergétique.
Portez cette bague pour une expérience quotidienne empreinte de sérénité et de connexion intérieure.
PIÈCE UNIQUE ( RARE), pierre naturelle, aucun traitement
Cette bague a été fabriquée à la main avec le plus grand soin.
Pour un ajustement parfait, consultez votre bijoutier de quartier.
Les anneaux des bagues peuvent être redimensionnés jusqu'à 4 tailles.
Conseils d'entretien pour préserver la beauté de vos bijoux :
- Conservez vos bijoux dans un endroit sec et dans des pochettes en tissu pour éviter les rayures.
- Retirez vos bijoux avant de vous baigner dans l'eau de mer ou de piscine, ainsi qu'avant de prendre une douche, car nos pierres sont naturelles et n'apprécient pas l'eau salée ou le savon.
- Évitez le contact de vos bijoux avec des parfums ou des crèmes.
- Ne portez pas vos bijoux lors d'activités de jardinage ou de bricolage.
- Retirez vos bijoux avant de pratiquer un sport en raison de la transpiration et avant de vous coucher.
Tous nos bijoux sont garantis pendant 2 ans
Garanties et sélection des pierres
Garanties et sélection des pierres
Les pierres ont toutes été sélectionnée par Magali lors de ses voyages. Chaque pierre est unique et taillée à la main. Elles peuvent donc présenter quelques variations de couleur et de forme. Les pierres peuvent également présenter des inclusions naturelles.
Pierres naturelles, aucun traitement.
Tous les bijoux a été fabriqué à la main avec soin par Magali dans son atelier boutique de Nantes ou par des artisans bijoutiers joailliers de confiance (à Nantes ou lors de ses voyages).
Conseils d'entretien
Conseils d'entretien
Conseils d'entretien de vos bijoux pour les garder brillants comme au premier jour :
- Conservez vos bijoux dans un endroit sec et dans des pochettes en tissus pour éviter les rayures
- retirer vos bijoux avant la baignade dans l'eau de mer ou de piscine, pas de douche ou de savons, nos pierres sont naturelles et n' apprécieront pas
- pas de parfum ou de crème en contact avec le bijou
- pas de jardinage et pas de bricolage avec le bijou. Certaines pierres sont très fragiles et peuvent se fissurer, voire casser au contact de chocs.
- retirer vos bijoux avant le sport à cause de la transpiration et avant de vous coucher.
Livraison et retours
Livraison et retours
Retour gratuit possible sous 14 jours.
Livraison offerte dès 250€ d'achats.
Tous les bijoux Maggy Holy Gems sont garantis 2 ans.
Voir l'intégralité de notre politique de retours.